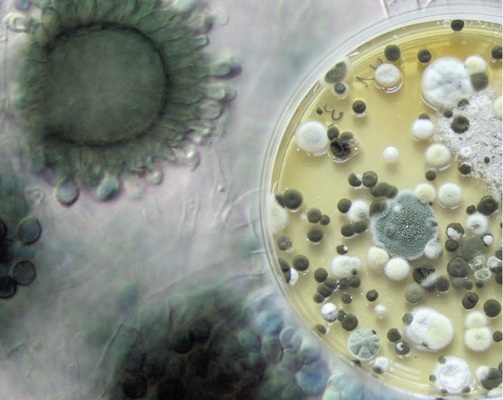
Unzureichendes Lüften oder Feuchteschäden begünstigen das Wachstum der Schimmelpilze. Ihre Sporen können allergische und reizende Reaktionen auslösen. Die Broschüre „Hilfe! Schimmel im Haus“ des Umweltbundesamtes beschreibt, wie man Schimmelpilze in Innenräumen erkennen und bekämpfen kann. Bestell- und Downloadtipp: www.umweltbundesamt.de/uba-info-medien/2227.html

Ursächlich für einen Befall ist ein Zusammenspiel von ungenügender Beheizung (aufgrund stark gestiegener Energiepreise), luftdichter Bauweise und bautechnischer Fehler (z.B. bei der Umsetzung von Dämmmaßnahmen). Die Vielzahl von Schimmelpilzfällen nach Wärmedämmmaßnahmen an Bestandsgebäuden haben zu der falschen Annahme geführt, dass durch die Maßnahmen ein Schimmelpilzbefall begünstigt wird. Aus bauphysikalischer Sicht ist jedoch genau das Gegenteil der Fall: Wärmegedämmte Gebäude sind im Vergleich zu den ursprünglichen Altbauten in Bezug auf die Nutzung „fehlertolerante Systeme“, da es aufgrund der höheren Oberflächentemperaturen und Entschärfung der Wärmebrücken auch bei höheren Raumluftfeuchten nicht zu einer schimmelpilzkritischen Tauwasserbildung kommt.
Allerdings sind hochwärmegedämmte Gebäude bauphysikalisch äußerst komplexe Systeme, die mit traditionellem Handwerks- und Planerwissen oft nicht mehr beherrscht werden. Entsprechend häufig sind Planungs- und Ausführungsmängel Ursachen eines Schimmelpilzbefalls.
Nutzerfehler oder baulicher Mangel?
Bei mietrechtlichen Auseinandersetzungen einer Schimmelpilz-Problematik geht es meist um Nutzerfehler bzw. bauliche Mängel. Auf der Nutzerseite ist vorrangig eine ungenügende Beheizung der Wohnräume festzustellen. Nicht gedämmte Gebäude müssen während der Heizperiode zwingend permanent auf 20 °C beheizt werden, um ein Auskühlen der Außenbauteile zu verhindern. Insbesondere ist ein Temperaturgefälle innerhalb der Wohnung (z.B. Wohnen – Schlafen) zu vermeiden, da die wärmere (feuchtere) Raumluft an den kalten Außenwänden schneller kondensiert. Ein falsch verstandener Energiespargedanke verursacht hier oft Schäden.
Da bisher ca. 50 Prozent der Gutachten zum Thema Schimmelpilzbildung mit dem einfachen Tenor „es wird nicht genug gelüftet“ schließen, wird aktuell (wegen der seit Mai 2009 in Kraft getretenen Lüftungsnorm DIN 1946-6) die Frage zu beantworten sein, ob bei einem zumutbaren Lüftungsverhalten (i.d.R. 3 Stoßlüftungen pro Tag) die eingebrachte Feuchte überhaupt abgeführt werden kann.
Der Winter ist zu warm
Bei den wärmeren Wintern sinkt der Feuchteabtransport durch einen Lüftungsvorgang drastisch, sodass bei einer Durchschnittstemperatur von ca. 7 °C in der Heizperiode zwischen 10 - 12 vollständige Luftwechsel erforderlich sind, um die vom Nutzer eingebrachte Feuchte wieder abzutransportieren.
Die nutzerunabhängige Lüftung wurde bisher fast ausschließlich von den vorhandenen Fugen – insbesondere an den Fenstern – erbracht. Durch die verschärften Energiesparanforderungen müssen diese Fugen jedoch bereits seit Jahren normgerecht abgedichtet werden, sodass in windschwachen Lagen ein Fenster im geschlossenen Zustand praktisch nicht mehr zum Luftaustausch beiträgt. Die einseitige Verschärfung an die Dichtheit der Gebäudehülle hat in den vergangenen 15 Jahren dazu geführt, dass kein ausreichender Luftwechsel in den Wohnungen mehr stattfindet. Hierdurch erhöht sich die Raumluftfeuchte und damit die Gefahr der erhöhten Bauteilfeuchten als Bedingung für einen Schimmelpilzbefall. Gleichzeitig steigt der CO 2 -Gehalt und die Schadstoffbelastung der Raumluft an, während der Sauerstoffgehalt durch den fehlenden Luftwechsel sinkt.
Die Bewertung von nicht gedämmten Altbauten wird sich daher in Zukunft stärker an der Gebrauchstauglichkeit orientieren müssen. Sofern an Wärmebrücken einstellige Oberflächentemperaturen vorliegen, bzw. der Feuchteabtransport nur durch ein unzumutbares Nutzerverhalten gewährleistet ist, muss davon ausgegangen werden, dass eine vertragsgemäße Gebrauchstauglichkeit nicht gegeben ist. Diese Feststellungen beträfe jedoch bereits Gebäude, in denen bereits vor 15 Jahren als alleinige Sanierungsmaßnahme die Fenster getauscht wurden.
Kritische Betrachtungsweisen an der DIN 1946-6
Seit Einführung der Wohnungslüftungsnorm DIN 1946-6 im Mai 2009 ist für Neubauten und (teil-)sanierte Bestandsgebäude ein ausreichender Luftwechsel zu planen und nachzuweisen. Seitdem wird in Fachkreisen viel über diese Norm kritisiert und diskutiert. Auch hier in der GLASWELT wurde ein kritischer Artikel (07.2011: „Fensterlüftung ausgeklammert“) veröffentlicht. Tenor ist meist, dass die Norm nicht anerkannte Regel der Technik sei und auch nicht werde. Kritisiert werden die Werte zum benötigten Luftaustausch und die automatisierte mechanische Lüftung. Auch wird darüber diskutiert, wie weit die Hinweispflichten beim Fensterbauer gehen, die ja bei Sanierungen und Einzelmaßnahmen von der Norm betroffen sind.
Vielfach wird nur der Aspekt der Beseitigung von Feuchtelasten bzw. die Lüftung zum Feuchteschutz besprochen. Ein weitaus höherer Lüftungsbedarf entsteht jedoch aus hygienischen Aspekten:
- Schadstoffabtransport: Ausdünstungen aus Möbeln und Baustoffen erfolgen kontinuierlich, sodass zur Begrenzung der Konzentration kurze Lüftungsintervalle oder eine permanente Grundlüftung erforderlich sind.
- Abtransport von Fasern, Partikeln und Allergenen in Form von Aerosolen und Stäuben, die entweder selbst eine Gefahr darstellen (Asbest, Pilzsporen, KMF) oder als Träger für schwer flüchtige Schadstoffe (z.B. PAKs, Biozide) dienen können.
- Begrenzung des CO2-Gehaltes und Versorgung mit Sauerstoff.
Die CO 2 -Konzentration ist ein allgemeiner Indikator für die Gesamtmenge der vom Menschen abgegebenen organischen Emissionen und Geruchsstoffen und damit gut zur Bewertung und Regelung der Notwendigkeit eines Lüftungsvorganges geeignet. Die Sicherstellung dieser hygienischen Lüftung wird durch die weiteren Lüftungsstufen in der DIN 1946-6 (reduzierte Lüftung, Grundlüftung und Spitzenlastlüftung) gewährleistet.
Die Anforderung an einen erforderlichen hygienischen Luftwechsel besteht allerdings nicht erst seit Änderung der DIN 1946-6. Auch in der DIN 4108-2 wurde schon die Forderung nach bis zu 12 vollständigen Luftwechseln am Tag gestellt. Leider wurde in der DIN 4108 nicht erläutert, wie und durch wen der notwendige Luftwechsel erbracht werden muss. Diese fehlenden Angaben führen bis dato zu der stetig anwachsenden Anzahl von juristischen Auseinandersetzungen mit einem Schimmelpilzhintergrund. Die regelmäßige Rechtsprechung betrachtet für Nutzer 2-3 manuelle Lüftungsvorgänge für zumutbar (selbst diese werden aber meist noch unzureichend und falsch ausgeführt). Es verbleiben aber nun noch bis zu 10 Luftwechsel, die vom Gebäude (welches dem Stand der Technik entsprechend abgedichtet ist) nutzerunabhängig erbracht werden müssen.
Nutzerverhalten ist nicht entscheidend
Aus dieser Sicht geht hervor, dass der Nutzer für die Lüftung nicht der entscheidende Faktor ist. Es gilt: Bei erhöhten Anforderungen an die Energieeffizienz wird generell das Festlegen von weiteren lüftungstechnischen Maßnahmen nach DIN 1946-6 notwendig. Der Fensterbauer muss zusätzlich beachten, dass der Mindestwärmeschutz zur Vermeidung von Tauwasser und Schimmelpilzbildung im Anschlussbereich des Fensters an der Leibung, Sturz und Sohlbank eingehalten wird. Dies kann er z.B. anhand des Beiblattes 2 der DIN 4108 oder von Wärmebrückenkatalogen (z.B. vom iBAT) oder über Berechnungen Finite Elemente Software (z.B. Win-Iso) nachweisen.
Problem: wenn das Fenster zu gut ist
Zusätzlich ist bei Fenstererneuerung im Gebäudebestand zu beachten: Die Anforderungen an den Mindestwärmeschutz lassen sich aufgrund der Bestandssituation z.T. nur eingeschränkt lösen. Wird der Mindestwärmeschutz aufgrund unzureichender Dämmeigenschaften der Außenwand oder aufgrund vorhandener massiver Wärmebrücken im Anschlussbereich (z.B. durchgehende Steinbank im Brüstungsbereich) nicht erfüllt, sind gegebenenfalls zusätzliche/flankierende Maßnahmen abzuwägen und zu planen. Besondere Vorsicht ist geboten, wenn das vorhandene Mauerwerk einen U-Wert> 1,0 W/m 2 K aufweist, sich Stahlträger im Sturz befinden, alte undichte ungedämmte Rollladenkästen vorhanden sind, durchlaufende Laibungsausbildungen bei altem mit Luftschicht oder Kerndämmung versehenem Mauerwerk oder durchlaufende thermisch nicht getrennte Fensterbänke vorhanden sind. Berücksichtigung findet dies zum Beispiel in der von einem Sachverständigen zu bestätigenden Bedingung, dass bei der KFW-geförderten Einzelmaßnahme Fenstertausch der U-Wert der Außenwand und des Daches kleiner sein muss als der UW-Wert der neu eingebauten Fenster und Terrassentüren (UW ≤0,95). Diese Maßnahmen sind daher eingeführt worden, da es nach dem Einbau von neuen wärmedämmenden und nahezu luftdichten Fenstern im Altbau mit unzureichender Wärmedämmung der Wände regelmäßig zu Problemen kam. Die alten Fenster waren meist die kältesten Bauteile in einem Altbau – hier konnte sich Kondensat an den Scheiben bilden, es wurde in Wasserrinnen auf den Fensterbänken gesammelt und anschließend entfernt. Diese Kondensatfalle entfällt nun bei den neu eingebauten Elementen. Das vorhandene Wasser in der Raumluft sucht sich nun die nächst kältere Stelle im Gebäude – meist die Außenwandecken, Fensterstürze oder Laibungen oder hinter Möbeln an Außenwänden. Der durch die alten undichteren Fenster mögliche Luftaustausch wird bei den jetzigen dichten Konstruktionen ebenfalls nahezu unterbunden, sodass es dadurch zu zusätzlichen Auffeuchtungen der Wohnraumluft kommt. Die betroffenen Bauteile durchfeuchten mit der Zeit immer mehr und dämmen dadurch schlechter – innenseitige Bauteiloberflächen werden noch kühler. Dadurch kühlt die Innenseite der Außenwand ab, höhere Feuchtigkeit entsteht an der Bauteiloberfläche und bildet einen geeigneten Lebensraum für Schimmelpilz. Es ist anschließend ein sehr hoher Energieaufwand nötig (Faktor 10), um die einmal gebundene Feuchtigkeit wieder aus den Materialien zu entfernen.
Die bestehenden Regelungen zum geplanten Luftaustausch an Gebäuden sorgen aktuell (wenn umgesetzt) und zukünftig dafür, dass sich u.a. die Schimmelproblematik deutlich reduzieren wird. Probleme durch nicht abgeführte Feuchte und Kondensat an Bauteiloberflächen und Konstruktionsfugen, die bis zum Ausfall der Bauteile (geöffnete Brüstungsfugen, abgerissene Leimverbindungen der Eckverbindungen, Lackabplatzungen etc.) führen können, werden dann im Regelfall der Vergangenheit angehören. Sicher wird an der ein oder anderen Stellschraube normativ noch gedreht werden. Ich bin beispielsweise der Meinung, dass mehr bedarfsgeführte Regelungen bei den Lüftungssteuerungen eingesetzt werden sollten (CO 2 - und luftfeuchtegeregelt).
Schimmelpilzbefallmit Asbestproblematikvergleichbar
Ist es bereits zu einem Schimmelpilzbefall gekommen, so besteht ein weiteres Problem: Den meisten Beteiligten ist nicht bekannt, dass es zum Umgang mit Schimmelpilzen diverse Verordnungen und Regelwerke gibt. Diese unterscheiden sich nur marginal von der Asbestproblematik. Die Grenzwerte sind äußerst eng gefasst und somit nicht immer „praxisgerecht“ (ein Befall von 0,5 m 2 ist bereits in die höchste Kategorie einzustufen). Es bedarf also bei der Bewertung eines gewissen „Fingerspitzengefühls“ um nicht gleich mit „Kanonen auf Spatzen zu schießen“, bzw. anderseits das bestehende Gefährdungspotenzial unbeachtet zu lassen. Im baupraktischen Alltag ist festzustellen, dass vorhandenen Schäden durch eine unsachgemäße Sanierung zumeist drastisch verschlimmert werden. Zuerst ist die Ursache des Befalls festzustellen und zu beseitigen. In der Praxis wird hingegen ein Befall zumeist nur oberflächig chemisch behandelt und übergestrichen. Eine Ursachenanalyse bzw. -beseitigung erfolgt i.d.R. nicht. Somit besteht die Gefahr eines kurzfristigen erneuten Befalls und einer zusätzlichen gesundheitlichen Belastung durch eingesetzte Chemikalien. Ein Schimmelpilzschaden muss daher durch zertifizierte Fachfirmen beseitigt und die Ursachen durch einen besonders geschulten Sachverständigen festgestellt werden. Eine Liste entsprechender Fachleute (auf Grundlage der Zulassungskriterien der Verbraucherzentrale) ist auf der Homepage des „Schimmelpilz-Hilfe-Forum“ in Form einer Postleitzahlsuche verfügbar.
Mehr Infos zur L��ftung
Hilfestellung für den Fensterbauer zur Umsetzung der DIN 1946-6 geben:
- VFF-Merkblatt ES.05: 2009-10 „Lüftung von Wohngebäuden-Gesundheit, Schadensvermeidung und Energiesparen“
- ift-Richtlinie LU-02/1: 2010-03 „Fensterlüfter-Teil 2: Empfehlungen für die Umsetzung von lüftungstechnischen Maßnahmen im Wohnungsbau“ (Vereinfachte Umsetzung von Lüftung mittels Fensterlüftern)
- ift Richtlinie LU-01/1: 2007-06 „Fensterlüfter-Teil 1: Leistungseigenschaften“
- Zusätzlich gibt es ein frei verfügbares Rechentool über https://www.ift-rosenheim.de/, mit dem aber nur die freie Lüftung berechnet werden kann.
Der Autor
Thomas Volmer betreibt in Brakel-Bökendorf als öffentlich bestellter und vereidigter Sachverständiger für das Tischlerhandwerk eine baubiologische Beratungsstelle und ein Sachverständigenbüro. Er ist als Gebäudeenergieberater und als zertifizierter Sachverständiger für Feuchte und Schimmelpilzbelastungen tätig. Außerdem arbeitet er als Auditor/ Güteprüfer beim ift Rosenheim und war bis 2007 selbst als Fensterbauer tätig.
Der Beitrag ist unter Zuhilfenahme von Fachbeiträgen des Sachverständigen für Schimmelpilzschäden, Schäden an Gebäuden und thermische Bauphysik Hans Westfeld aus Bielefeld entstanden.
www.svb-westfeld.de